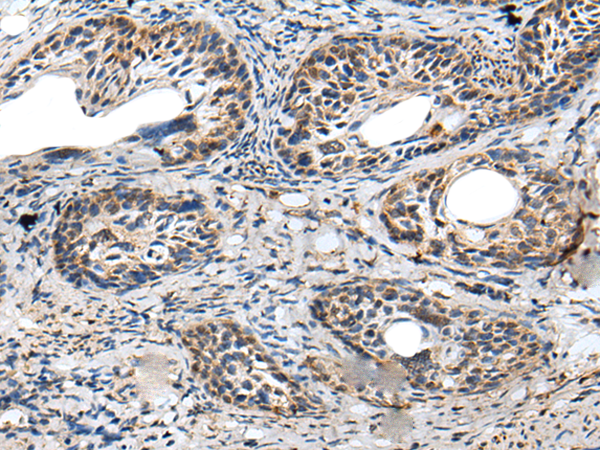

中文名稱: 兔抗PRNP多克隆抗體
英文名稱: Anti-PRNP rabbit polyclonal antibody
別 名: CJD; GSS; PrP; ASCR; KURU; PRIP; PrPc; CD230; AltPrP; p27-30; PrP27-30; PrP33-35C
抗 原: PRNP
相關類別: 一抗
儲 存: 冷凍(-20℃)
宿 主: Rabbit
反應種屬: Human, Mouse, Rat
標 記 物: Unconjugate
克隆類型: rabbit polyclonal
技術規(guī)格
|
Background: |
The protein encoded by this gene is a membrane glycosylphosphatidylinositol-anchored glycoprotein that tends to aggregate into rod-like structures. The encoded protein contains a highly unstable region of five tandem octapeptide repeats. This gene is found on chromosome 20, approximately 20 kbp upstream of a gene which encodes a biochemically and structurally similar protein to the one encoded by this gene. Mutations in the repeat region as well as elsewhere in this gene have been associated with Creutzfeldt-Jakob disease, fatal familial insomnia, Gerstmann-Straussler disease, Huntington disease-like 1, and kuru. An overlapping open reading frame has been found for this gene that encodes a smaller, structurally unrelated protein, AltPrp. Alternative splicing results in multiple transcript variants. |
|
Applications: |
ELISA, IHC |
|
Name of antibody: |
PRNP |
|
Immunogen: |
Fusion protein of human PRNP |
|
Full name: |
prion protein |
|
Synonyms: |
CJD; GSS; PrP; ASCR; KURU; PRIP; PrPc; CD230; AltPrP; p27-30; PrP27-30; PrP33-35C |
|
SwissProt: |
P04156 |
|
ELISA Recommended dilution: |
5000-10000 |
|
IHC positive control: |
Human brain and human breast cancer |
|
IHC Recommend dilution: |
25-100 |

購物車
幫助
021-54845833/15800441009
